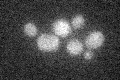
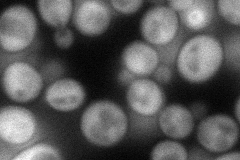
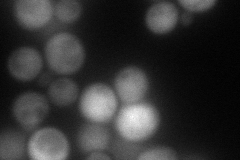
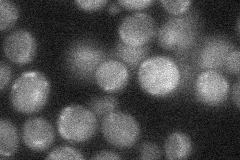

View description
Coupling protein that mediates interactions between the Ski complex and the cytoplasmic exosome during 3'-5' RNA degradation; eRF3-like domain targets nonstop mRNA for degradation; null mutants have superkiller phenotype
Localization:
Intensity:
Fold change:
Significance:
-
C’ GFP library in SD
below threshold16.97 -
N' NOP1pr-GFP in SD
cytosol71.0776 -
N' TEF2pr-mCherry in SD
cytosol77.8102 -
N' NATIVEpr-GFP in SD
below threshold23.6938 -
N' TEF2pr-VC and Cyto-VN in SD

cytosol37.0686 -
C’ GFP library in SD+DTT

cytosol17.251.01No -
C’ GFP library in SD+H2O2

cytosol17.571.03No -
C’ GFP library in Starvation Media

cytosol14.910.87No -
C’ GFP library on the background of Pup2-DaMP

below threshold -
C’ GFP library on the background of CCT mutant

below threshold19.61881.15573No
